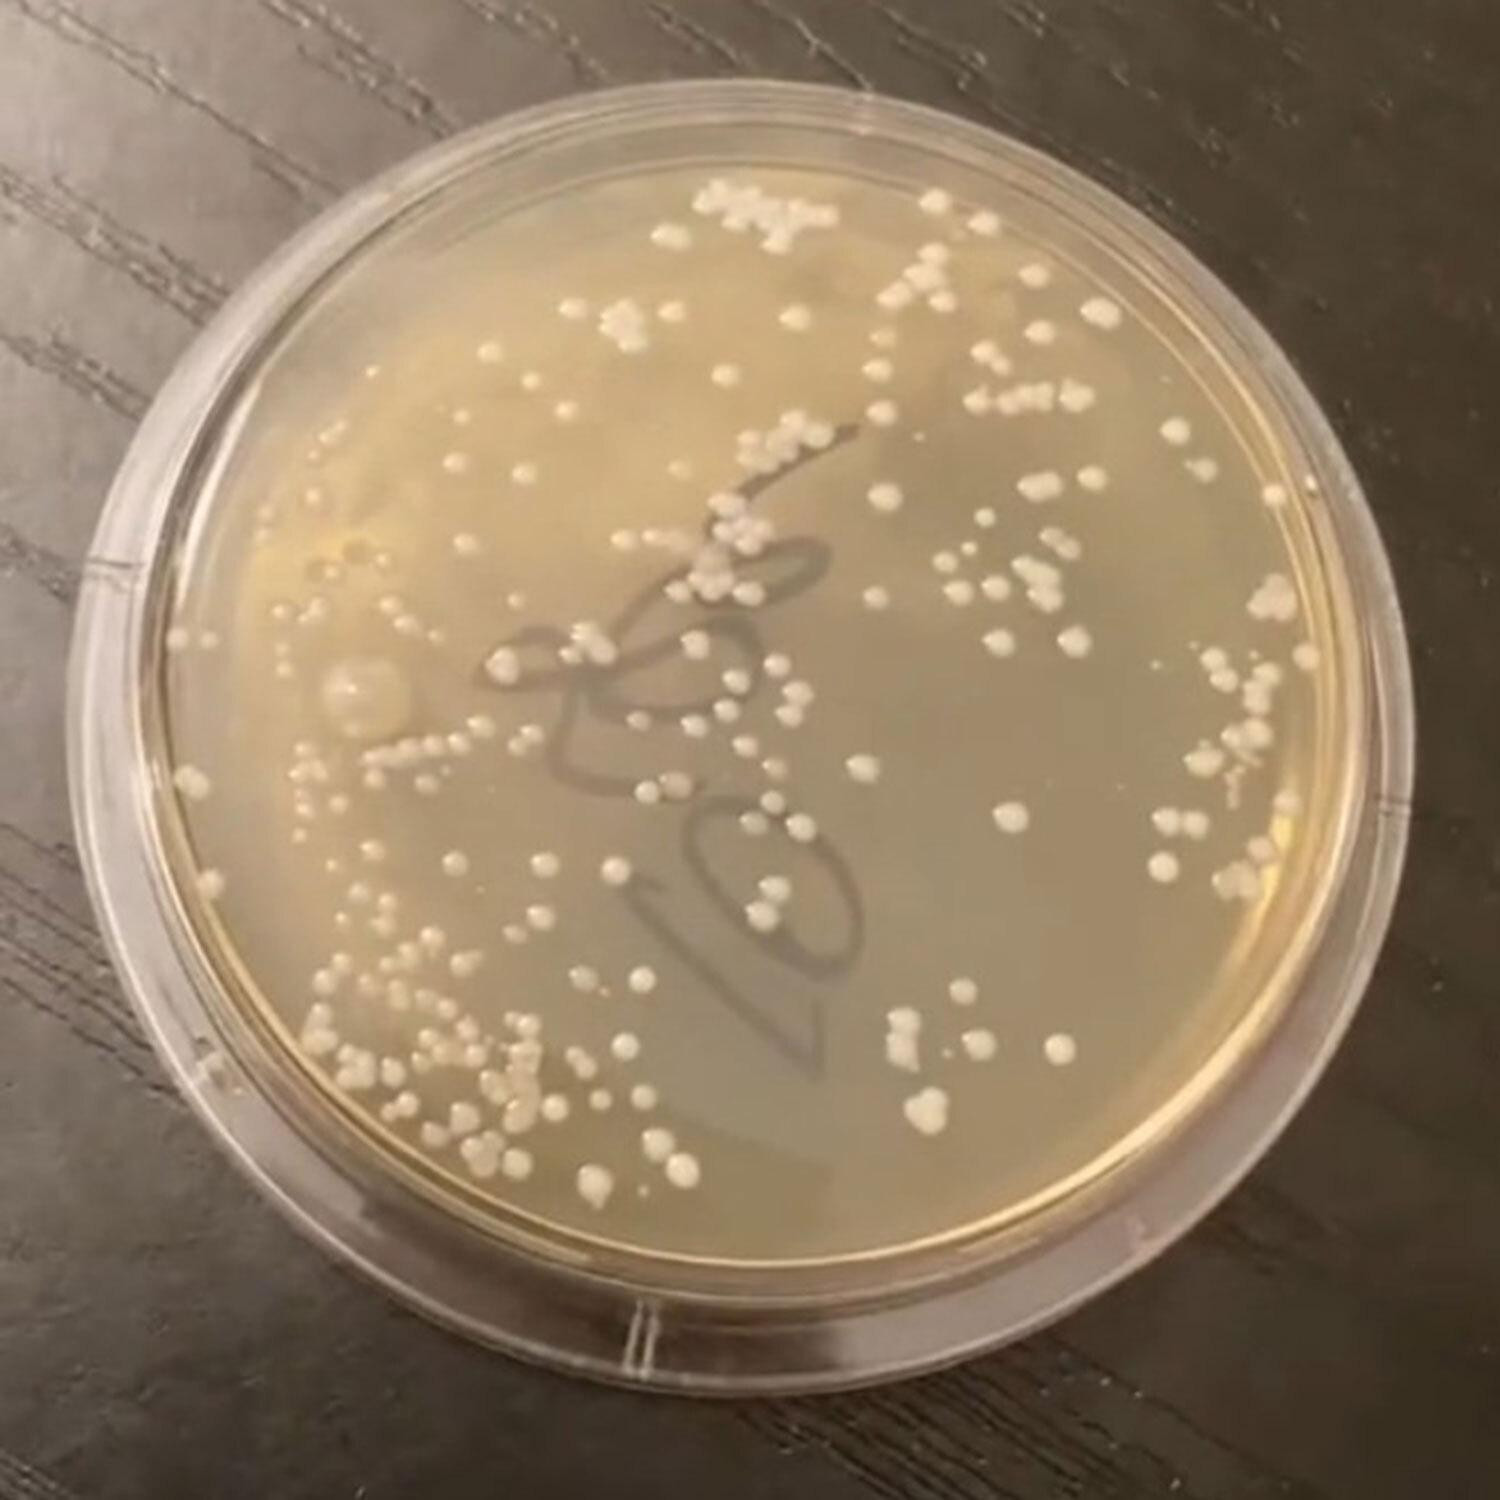

Da, istina je, kad kupimo neki novi odjevni predmet, želimo ga ponosno pokazati ‘urbi et orbi‘ čim prije. Neki od nas u toj pretjeranoj želji zaborave na važnu činjenicu - prije nas je taj isti odjevni predmet u kabini za isprobavanje robe isprobala i gomila ostalih kupaca!
Naročito je važno ‘ne zaboraviti‘ tu činjenicu kad su u pitanju kupaći kostimi. Nemamo svi iste higijenske navike, neki kupaće kostime (znamo, užas!) isprobavaju na golu kožu. Ta navika može izgledati bezazleno, no otkriće mikrobiologa Nicholasa Aichera pokazuje da je to itekako rizično.
Ovaj stručnjak za kontrolu kvalitete postao je poznat zahvaljujući svojim internetskim eksperimentima na TikTok profilu @howdirtyis, u kojima ispituje koliko bakterija živi na predmetima koje svakodnevno dodirujemo, a jedan od najnovijih izazova koje je odlučio provesti ticao se upravo higijenskih naljepnica na kupaćim kostimima.
U videu koji je privukao više od 5,6 milijuna pregleda na društvenim mrežama, Aicher je odlučio otkriti odgovor na pitanje koje malo tko postavlja: koliko su zapravo čisti kupaći kostimi koje isprobavamo prije nego ih kupimo? Na prvi pogled, higijenska naljepnica koja prekriva donji dio kostima trebala bi spriječiti bilo kakav izravan kontakt i time osigurati čistoću. No, uzorci koje je uzeo pokazali su drukčiju sliku. U trgovini je pažljivo uzeo briseve sa zaštitnih naljepnica na gaćicama dva bikinija, jedan narančaste, drugi tamnije boje, a zatim ih u laboratoriju prenio u inkubator kako bi se vidjelo što će iz njih izrasti.
Nakon određenog vremena, petrijeva posuda s uzorkom s narančastog bikinija pokazala je snažan i vidljiv rast bakterija. Aicher ih je identificirao kao Staphylococcus, vrstu koja prirodno živi na ljudskoj koži, ali može izazvati neugodne infekcije ako dospije u rane ili sluznice. Drugi uzorak, s tamnog bikinija, na prvi pogled je imao znatno manje kolonija, no pod povećalom su se vidjele sitne točkice iste bakterije.
Reakcije pratitelja bile su burne. Mnogi su priznali da će nakon ovoga dvaput razmisliti prije nego što isprobaju kupaći kostim izravno na tijelu. Jedna je žena komentirala kako kostime uopće ne isprobava, nego ih kupi i odmah opere, nadajući se da će veličina odgovarati. Druga je otkrila da u kupovinu kupaćih uvijek ide u uskim tajicama upravo iz higijenskih razloga. Bilo je i onih koji su, uz dozu humora, priznali kako im ovakvi eksperimenti podižu razinu tjeskobe, ali istovremeno pružaju i osjećaj olakšanja jer potvrđuju da njihova opreznost nije pretjerana.
Aicher je u razgovoru za portal What’s The Jam naglasio kako mu je cilj educirati javnost o ‘malim gadarijama‘ koje nas svakodnevno okružuju, a o kojima rijetko razmišljamo. Svojim testovima ranije je provjeravao bakterije na pumpama za gorivo, kvakama u javnim prostorima i testnim proizvodima u trgovinama ljepote. Svi ti predmeti, pokazalo se, kriju daleko više mikrobioloških (neugodnih) iznenađenja nego što bismo željeli znati.
Njegov eksperiment s kupaćim kostimima, iako jednostavan, snažno je odjeknuo jer pogađa nešto što je mnogima dio uobičajene rutine. Ljetni mjeseci, kupovina novih komada odjeće za plažu, isprobavanje pred ogledalom, sve to izgleda bezopasno dok ne shvatimo da svaka tkanina, čak i ona koja se čini potpuno nova, može nositi tragove prethodnih dodira i izloženosti.
Higijenska naljepnica očito nije nepremostiva barijera za bakterije, pa je zato osnovno pravilo koje Aicher ponavlja vrlo jasno: kupaći kostim uvijek isprobavajte preko donjeg rublja ili tanke odjeće, a prije prvog nošenja ga operite, po mogućnosti i dva puta.
Ova priča djeluje i kao podsjetnik da se zdrav razum i osnovne higijenske navike nikada ne bi smjele zanemariti, čak ni u naizgled banalnim situacijama poput kupovine kupaćeg kostima. Možda će vas podsjetiti da odjenete tanke tajice u idući shopping ili barem da nakon kupnje odmah uključite perilicu rublja, jer i ono što izgleda novo i čisto može skrivati mikrobiološku priču koja je sve samo ne bajka.

Za sudjelovanje u komentarima je potrebna prijava, odnosno registracija ako još nemaš korisnički profil....